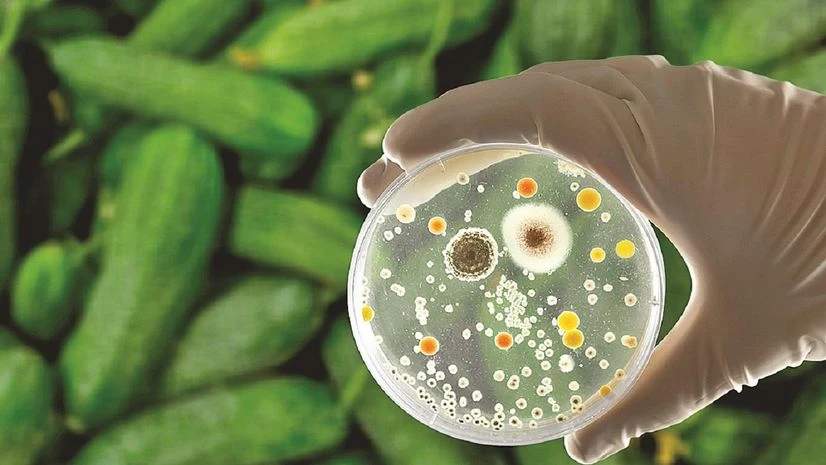
E. Coli E. Coli

Moves by major U.S. fast-food chains to temporarily pull fresh onions off their menus on Thursday, after the vegetable was named as the likely source of an E. coli outbreak at McDonald's, laid bare the recurring nightmare for restaurants: Produce is a bigger problem for restaurants to keep free of contamination than beef.
Onions are likely the culprit in the McDonald's E. coli outbreak across the Midwest and some Western states that has sickened and killed one. McDonald's at one-fifth of its 14,000 U.S. restaurants.
Of the 61 people on whom information was available, 22 were hospitalized, and two developed hemolytic uremic syndrome, a serious condition that can cause kidney failure, the U.S. Food and Drug Administration said on Friday.
In past years, beef patties dominated the dockets of foodborne illness lawyers, before U.S. federal health regulators cracked down on beef contamination after an E. coli outbreak linked to Jack in the Box burgers hospitalized more than 170 people across states and killed four. As a result, beef-related outbreaks became much rarer, experts say.
"Produce is a much harder problem," said Mike Taylor, a lawyer who played leadership roles in safety efforts at the FDA and the U.S. Department of Agriculture, and today is on the board of a nonprofit called STOP Foodborne Illness.
Also Read
Experts say the biggest difference is that beef is cooked while fresh produce, by definition, is not cooked. Proper cooking is a "silver bullet" against contamination, said Donald Schaffner, a Rutgers University food science and safety expert.
Large-scale industrial produce is washed, sanitized and tested to a similar degree that beef is, but tests cannot catch sufficiently low levels of contamination, experts say.
Crops are often grown outdoors, where feces from wildlife or nearby agricultural animals can seep into irrigation water or floodwater. E. coli is a normal pathogen in the guts of animals.
Cattle have it more than others, but it has also been detected in geese, boars, deer and others, said Mansour Samadpour, a food safety specialist.
Contamination could arise from using untreated manure or contaminated irrigation water, or from holding or slicing the onions in a way where they became contaminated, Schaffner said.
Samadpour, who is chief executive of IEH Laboratories and Consulting Group, and who was hired by Chipotle to overhaul its food safety regime after a series of contamination episodes in the mid-2010s, said U.S. Department of Agriculture officials insisted on stronger testing of beef. "We went from one or two beef recalls a month to one recall every year or three," Samadpour said.
Similar rigorous testing is applied to produce, and fast-food chains and other buyers often require it. But tests do not detect everything. The cleaner the product, the harder it is to detect, Samadpour said.
TOUGHER REGULATIONS
Both McDonald's and Taylor Farms, a supplier of yellow onions to McDonald's in the affected states, are large and sophisticated companies, and widely regarded by food safety experts as standard-bearers for safe practices.
McDonald's suppliers test produce frequently and did so in the date range given by the Centers for Disease Control and Prevention for the outbreak, and none of them identified this E. coli strain, company spokespeople said.
Wendy's in 2022 pulled lettuce from restaurants in several states after the CDC suspected it was the source of an E. Coli outbreak that sickened dozens. In 2006, lettuce from Taco Bell was identified as the likely source of an E. coli outbreak that sickened 71 people. Taco Bell is currently owned by Yum Brands.
Contamination can extend even beyond pathogens such as E. coli and salmonella. McDonald's previously dealt with a parasitic outbreak in 2018 linked to McDonald's salads that sickened nearly 400.
The Food Safety Modernization Act of 2011 required the Food and Drug Administration to establish standards for the safe production and harvesting of fruits and vegetables. The FDA introduced regulations for farm produce that previously was not subject to much regulation, Rutgers' Schaffner said.
“Very often the pattern is we have a public health problem or a food safety problem and eventually Congress will react and we’ll have regulations," Schaffner said.
Taylor, the former FDA official, said that while beef contamination was more or less solved through government regulation, improving the safety of produce is best left to buyers, such as McDonald's and other fast-food chains.
Taylor believes the fast-food chains and grocery stores, as major buyers of produce, can collectively "modernize and harmonize" the standards they expect from suppliers. The produce marketplace is fragmented and diverse.
"The only thing that could for sure destroy the microbes is radiation - but no one wants it," food-safety expert Samadpour said. It is impractical at the volumes of produce that are sold, he said. In addition, for many people radiation carries an "ick factor" when applied to food.
)